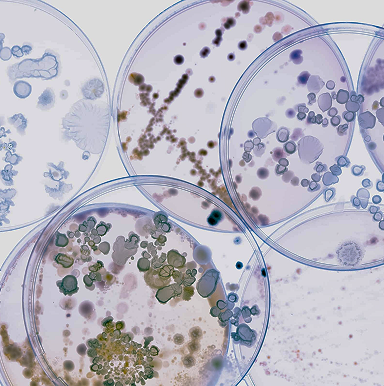

.avif)
Portfolio
Transforming innovation into impact.
Portfolio companies

AdvanCell

AdvanCell
A Brisbane-based radiopharmaceutical company in the clinic with their novel targeted alpha therapies based on lead-212 aimed at improving survival and quality of life for patients with cancer.

Amaroq Therapeutics

Amaroq Therapeutics
A biotechnology company focused on developing a new class of therapeutics that target IncRNA in cancer.

Antares Therapeutics

Antares Therapeutics
Transforming patient lives through pioneering precision medicines.

Aravax
.png)
Aravax
Clinical stage biotech developing a safe and convenient novel peptide immunotherapy for peanut allergy.

Carina Biotech
.png)
Carina Biotech
Clinical stage immunotherapy developing and manufacturing CAR-T therapies for colorectal cancer.

Creyon Bio

Creyon Bio
An AI-driven drug development company developing tissue-specific, RNA-targeted nucleic acid therapies designed to potentially improve safety, efficacy, and patient adherence in neuromuscular, CNS, and immunology indications.

CurveBeam AI
.png)
CurveBeam AI
Commercial manufacturer of bilateral weight bearing tomography scanners for orthopaedics.

Emyria

Emyria
Pioneering a new model of multi-disciplinary clinical services that collect critical patient data, supporting an innovation pipeline of new care models and novel drug development. Specialty clinics designed for world-class learning environments to rigorously test new therapies, including MDMA-assisted treatment for PTSD, while advancing the development of novel compounds that target key neurotransmitters like serotonin and dopamine.

Inventia Life Science
.png)
Inventia Life Science
3D bioprinting company that has developed a high-speed and ultra-high-throughput cell printer (RASTRUM) for advanced cell models.

Kantoko
.png)
Kantoko
Online platform seamlessly connecting you with accredited ADHD specialists for personalised diagnosis and treatment plans.
.png)
LimmaTech Biologics
.png)
LimmaTech Biologics
A clinical stage biotechnology company developing innovative vaccines targeting AMR with their lead focus on Shigella (Phase II) and clinical programs in Staphylococcus (Phase I) & Gonorrhoea (Phase I/II).

Lumos Diagnostics
.png)
Lumos Diagnostics
Specializes in rapid, cost-effective and complete point-of-care (POC) diagnostic test technologies with their flagship proprietary product FebriDx being a POC test which is able to distinguish between bacterial and viral infections in less than 10 minutes.

Mindset Health
.png)
Mindset Health
Creates mobile hypnotherapy programs that help people manage and improve their health, without drugs or diets with key digital therapeutic apps for IBS (Nerva), Mental Health (Claria), Chronic Back Pain (Relio), Menopausal Hot Flashes (Evia) and Smoking Cessation (Finito).

Perx Health

Perx Health
A digitally-scaled care management program that uses daily, persistent motivation to deliver 90% adherence, >44x longer engagement and >6x ROI with high-risk members managing chronic conditions.

Proton Intelligence

Proton Intelligence
Building the first real-time potassium monitoring wearable, allowing clinicians to treat and manage kidney disease patients more safely and precisely.

Proxima Bio

Proxima Bio
Developing next generation cell surface degraders. Their technology provides new opportunities to target previously undruggable, disease-causing proteins, with powerful potential applications in autoimmune conditions and cancers.

Rekover Therapeutics

Rekover Therapeutics
A lead program is advancing a drug aimed at remyelinating neurons in patients with multiple sclerosis with the potential to reverse the negative effects of neurodegeneration.
Revagenix
.png)
Revagenix
AMR focused biopharma developing novel antibiotics for drug-resistant infections with an initial focus on complex UTI (cUTI).

Rock Health

Rock Health
A venture fund that invests in entrepreneurs building remarkable businesses where healthcare and technology intersect.

SpeeDx
.png)
SpeeDx
Testing kits focused on highly accurate multiplex analysis used by pathology labs currently for respiratory diseases & STIs.

Stamford Pharmaceuticals

Stamford Pharmaceuticals
Developing a gene therapy for advanced forms of skin cancer, specifically locally advanced and multi-lesion basal cell carcinoma's (BCC).

Sweetch
.png)
Sweetch
A digital health company that partners with pharmaceutical and medical device manufacturers to improve medication adherence and patient education Sweetch is primarily in the diabetes and anti-obesity markets which are being driven by the new class of GLP-1 agonists and projected to reach >$100B by 2035.

Syndeio

Syndeio
A clinical-stage precision neuroscience company developing a family of first-in-class compounds targeting depression using a ketamine-inspired mechanism of action, but bypassing hallucinogenic effects. The two lead compounds Zelquistinel and Apimostinel are undergoing Phase 2 trials for MDD and acute depression, respectively.

Tin Alley Ventures

Tin Alley Ventures
We invest from seed to pre-IPO across all sectors, though our primary disciplines are life sciences and physical sciences. We invest in globally competitive, high impact companies founded by researchers, students and alumni of the University of Melbourne and its affiliated institutes.

Verge Genomics

Verge Genomics
A leading AI drug discovery company that are able to find new targets to treat disease. They have focussed their platform on neurological and autoimmune diseases and have an exciting ALS drug (with a novel PIKfyve pathway) that has completed a Phase I trial. They have signed multiple partnership agreements with Eli Lilly and Astra Zeneca worth up to US$1.6B.
.png)
Xylo
Manufacturer and developer of 5HT2A small molecules for mental health disorders using a novel computational approach.

Yosemite

News & updates
How we support you
Strategic guidance
From IP and clinical strategy to go-to-market execution.
Global market access
Direct introductions to US/EU partners, investors, and health leaders.
Talent network
Access to top biotech, medtech, and healthtech talent.
Capital beyond seed
Evergreen business model and strong international co-investor networks.
Deep domain expertise
MDs, PhDs, pharma, tech transfer, and investment banking experience.
Ecosystem advocacy
Promoting your success within the health innovation community.



.png)

.png)
.png)

.png)
.png)
.png)
.png)
.png)
.png)
.png)
.png)
.png)

